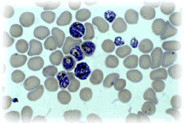

Introducción
|
|
Las distintas especies de plasmodios en América, no sólo han tenido un origen distinto, sino que encontraron un gran espectro de especies de anofelinos susceptibles desde los Estados Unidos de Norteamérica hasta el norte de Argentina, conjuntamente con el hecho de afectar al continente más heterógeneo desde el punto de vista genético, al estar conformado por amerindios (indoasiáticos), caucásicos-mediterraneos y población negro-africana. Este proceso es completamente diferente al del continente africano, donde la larga coevolución de los parásitos maláricos con una población etnicamente mas homogénea, permitió la inducción y expresión de fenotipos condicionantes de la resistencia a la infección por estos hemoparásitos (hemoglobinopatias tales como la presencia de hemoglobina S, enzimopatías como la deficiencia de la glucosa-6-fosfato deshidrogenasa, ausencia del grupo Duffy, mutaciones como la de la banda 3 que ocasiona ovalocitosis). En otras palabras, los parásitos maláricos actuaron como una fuerza selectiva, la cual si bien indujo la aparición de genes perjudiciales, éstos, le han dado ventaja selectiva a las poblaciones de origen africano. (Miller, L. 1994). La ausencia del grupo Duffy, receptor eritrocítico de los merozoitos de P. vivax ha limitado la dispersión de esta especie en Africa, al contrario de lo ocurrido en el continente americano.
Con estas herramientas, se inicia la estructuración de los primeros programas de control de malaria en el continente a comienzos de siglo, pero con mayor énfasis a partir de las décadas de los años 30 a los 50. La eficacia de estos programas, permitió una notable disminución de las tasas de morbilidad y mortalidad en toda América. Desapareció la transmisión en los Estados Unidos, en algunas islas del Caribe, el norte de Argentina y algunas áreas de los países centro y suramericanos, de los cuales la más importante correspondió a Venezuela, donde se logró erradicarla de un tercio del territorio (Fig.1b). De hecho fue el primer país del trópico en decretar un área de malaria erradicada y certificada por la OPS. (Gabaldón A. 1949 y Gabaldon and Berti. A., 1954).
Evolución
|
El rápido avance en el saneamiento de grandes áreas geográficas en Estados Unidos, Venezuela, Argentina y Ecuador, estimuló a que la Organización Panamericana de la Salud (OPS) estableciera, la estrategía de erradicación de la malaria en la XIV Conferencia Panamericana de la Salud celebrada en 1954 (Litsios S. 1998). Esta estrategía fue revertida hacia el control de la malaria y su integración a los programas de atención primaria de salud, en sucesivas Asambleas de la Organización Mundial de la Salud, celebradas en 1969, 1973, 1985 y 1992. (Litsios S. 1998; Roberts D. 1997). Ecuador y México son los únicos paises en América que siguen implementando programas de control que no siguen los principios de la estrategia global para el control de la Malaria (OPS, 1997) y que por cierto, son de los paises con menor Incidencia Parasitaria Anual (IPA). Venezuela, es uno de los países en el continente, que asumió parcialmente los postulados de la OMS, contradiciendo los postulados de Arnoldo Gabaldón quien mantuvo un rumbo distinto al recomendado por la OPS y la OMS (Litsios S 1998). |
Es preciso, evaluar y comparar las estrategías adoptadas por países como Colombia y Brasil, quienes eliminaron sus respectivos programas de control de la malaria, el SEM y la SUCAM, con aquellos de la región donde todavía persisten estructuras sanitarias especializadas en el control de enfermedades metaxénicas como en el caso de Venezuela, la Dirección General Sectorial de Malariología y Saneamiento Ambiental.
Los cambios organizativos de los ministerios de la salud regionales, coincidieron con el proceso de descentralización en algunos países, lo cual afectó la eficiencia de los programas de control, al transferirse recursos económicos sin previamente valorar las capacidades regionales. En el caso de Venezuela, se agravó el problema malárico en algunos estados y en consecuencia, fueron intervenidos por el gobierno central, como es el caso del estado Bolívar en 1998.
 Se observa un lento pero sostenido deterioro de la situación malárica en América desde 1970, (Figura 1) pues el IPA (Incidencia Parásitaria Anual x 1000 habitantes) se ha duplicado en este período (1,89 en 1970 vs 3,82 en 1996) (OPS, 1997). El índice de láminas positivas (ILP) casi se ha cuadruplicado en el mismo período, debido no sólo al incremento de la transmisión, sino también al incremento de la búsqueda pasiva al cambiar la estrategia de control de la malaria. La Tabla I muestra algunos indicadores malariométricos medidos en este último cuarto de siglo. Aproximadamente se diagnostica un promedio de un millón de casos de malaria por año, si bien se desconoce actualmente el grado de subregistro. A diferencia de lo observado en el continente africano, los portadores asintomáticos en América son poco frecuentes (Prata, A. et al, 1988), aunque los nuevos métodos de diagnóstico con técnicas de biología molecular parecieran indicar lo contrario en algunas áreas geográficas (Pérez, H. et al 1998).
Se observa un lento pero sostenido deterioro de la situación malárica en América desde 1970, (Figura 1) pues el IPA (Incidencia Parásitaria Anual x 1000 habitantes) se ha duplicado en este período (1,89 en 1970 vs 3,82 en 1996) (OPS, 1997). El índice de láminas positivas (ILP) casi se ha cuadruplicado en el mismo período, debido no sólo al incremento de la transmisión, sino también al incremento de la búsqueda pasiva al cambiar la estrategia de control de la malaria. La Tabla I muestra algunos indicadores malariométricos medidos en este último cuarto de siglo. Aproximadamente se diagnostica un promedio de un millón de casos de malaria por año, si bien se desconoce actualmente el grado de subregistro. A diferencia de lo observado en el continente africano, los portadores asintomáticos en América son poco frecuentes (Prata, A. et al, 1988), aunque los nuevos métodos de diagnóstico con técnicas de biología molecular parecieran indicar lo contrario en algunas áreas geográficas (Pérez, H. et al 1998).
Brasil notificó en 1996, 455.194 casos que corresponden al 39,1% de todos los casos del continente seguido de Perú, Honduras y Nicaragua (Figura. 2). El número de casos notificados por estos países corresponde al 83,7% del total de casos del continente. Sin embargo, en relación al riesgo, los países con mayores cifras de incidencia malárica son la Guyana Francesa (IPA = 309), Suriname, Brasil, Perú y Belize (Fig. 3) (OPS, 1997).
La fórmula parasitaria muestra predominio de P.vivax, especie que para 1996 representó el 75,5% de los casos, seguido por P.falciparum con el 24,3% y P.malariae 0,17%.
Existe una clara periodicidad anual de la transmisión malárica asociada con la entrada y salida de las lluvias (estacional) la cual condiciona un incremento de la densidad de los vectores. Adicionalmente a ello, Gabaldón describió por vez primera la existencia de una periodicidad interanual cada cinco años, la cual denominó paraquinquenal (Gabaldón A. 1949). Esta periodicidad no pudo ser nunca explicada por Gabaldón. No fue sino recientemente que Bouma y col. (Bouma et al, 1997a; Bouma et al 1997b) lograron asociarla con el fenómeno de El Niño, que afecta con mayor intensidad a Centro y Sur América. En el caso de Venezuela y Colombia, la incidencia malárica se incrementa al año siguiente del fenómeno de El Niño, sugiriendo que este fenómeno pudiera servir como predictor de epidemias. No obstante, las variaciones pudieran asociarse a otros factores, como los de tipo administrativo, pues, existe una relación inversamente proporcional entre inversión en salud y los indicadores malariométricos. (Figura 3). El deterioro progresivo de la situación malárica ha coincidido con el cambio en las estrategias de control de la malaria (Roberts, D. 1997) y posiblemente exacerbado por factores administrativos (ineficacia de los programas), políticos (desinversión), sociales (desarrollos mineros y madereros, etc.), biológicos (aparición y dispersión de anofelinos resistentes a los insecticidas, resistencia de los parásitos maláricos a los medicamentos). (Molina D. y col. 1997; Riggione, F. y col. 1998; Segurado, A. y col. 1997). Otros autores defienden el cambio de estrategia iniciado por la OMS/OPS y basan su exito en la reducción de los costos (OMS/OPS 1997) sin analizar el incremento del número de casos y sin mencionar el costo creciente de los enfermos y muertes por malaria.
Es justamente en América donde se describe por primera vez algunos de estos problemas, como es el caso de la resistencia a los antimaláricos. Lo hace Maberti S. en 1960. Lo más grave, es que hasta ahora sólo se había observado resistencia a la quimioterapia con P. falciparum y ahora se suma la de P. vivax a Primaquina (Phillips E. et al 1996; Nayar, J. et al. 1997).
Un resumen general de las características epidemiológicas de la malaria en América se presenta en la Tabla II.
Perspectivas
 Persiste la tendencia de agravamiento de los factores sociales, culturales, político-administrativos y biológicos responsables de la transmisión malárica en América. Sumado a ello, los cambios climáticos estan ocasionando cambios en los hábitats de los anofelinos, cambios en la capacidad vectorial que pudieran incrementar la transmisión malárica. (WHO, 1996). Se ha estimado que cambios de temperatura en el mundo de 1 a 3 grados centígrados previstos para el año 2100, aumentará al doble la capacidad vectorial de los anofelinos en los paises tropicales y aproximadamente 100 veces en los de clima templado (WHO, 1996). Estos fenómenos parecieran indicar la aparición de nuevas áreas maláricas antes refractarias (transmisión a mayor altitud como está ocurriendo en Sierra Parima en la frontera de Brasil y Venezuela) y la presión constante de la reintroducción en áreas previamente maláricas. Sólo en Estados Unidos han surgido 57 brotes con trasmisión local entre 1940 y 1996. (MMWR, 1997).
Persiste la tendencia de agravamiento de los factores sociales, culturales, político-administrativos y biológicos responsables de la transmisión malárica en América. Sumado a ello, los cambios climáticos estan ocasionando cambios en los hábitats de los anofelinos, cambios en la capacidad vectorial que pudieran incrementar la transmisión malárica. (WHO, 1996). Se ha estimado que cambios de temperatura en el mundo de 1 a 3 grados centígrados previstos para el año 2100, aumentará al doble la capacidad vectorial de los anofelinos en los paises tropicales y aproximadamente 100 veces en los de clima templado (WHO, 1996). Estos fenómenos parecieran indicar la aparición de nuevas áreas maláricas antes refractarias (transmisión a mayor altitud como está ocurriendo en Sierra Parima en la frontera de Brasil y Venezuela) y la presión constante de la reintroducción en áreas previamente maláricas. Sólo en Estados Unidos han surgido 57 brotes con trasmisión local entre 1940 y 1996. (MMWR, 1997).
Es por ello imprescindible, tratar de modular todos estos factores, en lo particular el desarrollo social que permita una relación armónica consigo misma y su entorno, evitando el deterioro en la salud y calidad de vida de la población. Concomitantemente, es necesario el desarrollo de nuevas herramientas para el control del vector y el parásito. En este sentido, uno de los grandes aportes recientes del Continente Americano en el control de la malaria ha sido el desarrollo de una vacuna contra la malaria. Patarroyo, investigador colombiano publica en 1988 el primer ensayo clínico exitoso de una vacuna químicamente hecha contra P. falciparum. En Venezuela se realiza el primer ensayo en población civil (Fase III) de esta vacuna (Noya et. al 1994) y posteriormente, la evaluación conjunta por Meta-analisis de los estudios en América Latina, Africa y Asia (Graves et al 1998), confirman la eficacia de la vacuna SPf66.
Este ha sido un siglo muy fructifero en cuanto a investigación en malaria y los aportes de investigadores del continente americano. Es de destacar que la pionera actividad de Willian Gorgas, Paul Russell, Fred Soper, Carlos Chagas y Arnoldo Gabaldón, se cierra con los aportes invalorables de Trager y Jensen quienes en 1976 cultivan por primera vez a P. falciparum, permitiendo el desarrollo explosivo de la investigación sobre esta especie en el laboratorio y cerrando el ciclo a finales de siglo con el aporte fundamental de los esposos Nussengweig (Nussenzweig V. ad Nussenzweig R. 1989) que sentaron las bases para el desarrollo de vacunas antiesporozoiticas y finalmente el de Manuel Elkin Patarroyo, quien demostró por vez primera la posibilidad de desarrollo de una vacuna contra la malaria y además por la vía de la síntesis química. (Patarroyo et al 1988).Referencias
-
Bouma, M. and Dyc C. 1997. Cycles of malaria associated with El Niño en Venezuela. JAMA: 278: 1772 - 1774
-
Bouma, M. J. Poveda G., Rojase W. Chavasesee DEE., Quiñonese M., Cox J. ande Patz J. 1997. Predicting high - sish years for malaria in Colombia using parameterse of El Niño SEouthen Osecillation. Trop. Mede. Int. Health 2: 1122 - 1127
-
Chagas C. 1906. Prophylaxia do impaludismo. Brazil - Médico. XX: 419 - 422.
-
Gabaldón, A. 1949. The nation - wide campaing against malaria in Venezuela.Trans. R. Soc. Trop. Med. Hyg. 43: 113 - 164.
-
Gabaldón, A. and Berti, A. 1954. The first large area in the tropical zone to report malaria eradication: north - central Venezuela. Am. J. Trop. Med. Hyg. 8: 793-807
-
Graves P., Gelband H. and Garner P. 1.998. The SPf66 malaria vaccine: What is the evidence for efficacy?. Parasitol. Today. 14:218-220
-
Gabaldón, A. 1972.Origen de la malaria americana. Bol. Dir. San. Amb. XII: 99-100.
-
Knell A. J. 199. Malaria. Oxford University Press. Oxford.
-
Litsios S. 1998. Arnoldo Gabaldón's independent path for malaria control and public health in the Tropics: a lost " paradigm" for WHO. Parassitologia 40 : 231-238.
-
Maberti, S. 1960. Desarrollo de ersistencia a la pirimetamina. Presentación de 15 casos estudiados en Trujillo, Venezuela. Arch. Ven. Med. Trop. Parasitol. Med. III. 239-259
-
Miller L. H. 1994. Impact of malaria on genetic polymorphism and genetic diseases in Africans and African Americans. Proc. Natl. Acad. Sci. USA. 91: 2415 - 2419.
-
Molina de F., D., Saume, F. Bisset, J., Hidalgo, O. y col. 1997. Establecimiento de la línea de suceptibilidad de la fase adulta de Anopheles spp. a insecticidas químicos. Bol. Dir. Mal. San. Amb. XXXVII (1y2): 55-69
-
Nayar J.K., Baker R. H., Knight J. W., Sullivan J.S., Mons C.L, Richardson B.B., Galland G.G. and Collins W.E. 1997. Studies on primaquine-tolerant strain of Plasmodium vivax from Brazil in Aotus and Saimiri monkey. J. Parasitol. 83:739-745
-
Noya O., Gabaldón Y., Alarcón de Noya B., Borges R., Zerpa N., Urbaez J. et al. 1994. A population-based clinical trial with the SPf66 synthetic Plasmodium falciparum malaria vaccine in Venezuela. J. Infect. Dist. 170:396-402
-
Nussenzweig V. and Nussenzweig R. 1989. Rationale for the development of an engineered sporozoite malaria vaccine. Adv. Inmunol. 45:283-334
-
OPS. 1997. Situación de los programas de malaria en las americas. XLV Informe. Documento CD 40/<INF/2. p.25.
-
Patarroyo M., Amador R., Clavijo P., Moreno A., Guzmán F., Romero P., Tascon R., Franco A., Murillo L., Ponton G. and Trujillo G. 1998. A synthetic vaccine protects humans against challenge with asexual blood stages Plasmodium falciparum malaria. Nature 332:158-161
-
Pereira C. A. 1985. Conseide sobre el deiagnósetico y la certificación dee muerte por malaria. XXII Aseamblea ee- Prata A. Urdeaneta M., Mc Greevy P. ande SEhugiro M. 1988. Infrequency of aseymptomaetic malaria in an endeemic area in Amazonase, Braseil. Rev. SEoc. Brase. Med. Trop 21: 51 - 54
-
Phillips E.J. Keystone J.S. and Kain K.C. 1996. Failure of combined chloroquine and high-dose primaquine therapy for Plasmodium vivax malaria acquired in Guyana, South America. Clin. Infect.Dist. 23:1171-1173
-
Postigo M., Mendoza-Leon A. and Perez H. 1998. Malaria Diagnosis by the polymerase chain reaction: a field study in south-eastern Venezuela. Trans. R. Soc. Trop. Med. Hyg.92:509-511
-
Prata A., Urdaneta M., Mc Greevy P. and shugiro M. 1998. Infrequency of asymtomatic malaria in endemic area in Amazonas, Brasil. Rev. Soc. Bras. Med. Trop. 21:51-54
-
Riggione F., Magris, M. Serafín, LM., Mijares G. Charris, J. Dominguez, J. y Urbina, J. 1998. La quimiosensibilidad de Plasmodium falciparum en Venezuela. Bol. Dir. Mal. y San. Amb. XXXVIII (1):1-13
-
Roberts D. R. 1997. DDT, global strategies and a malaria control crisis in South America. Em. Infect. Dis. 3:
-
Russell P., West, Manweld R. and Macdonald G. 1963. Practical Malariology Oxford University Press. London.
-
Segurado A., di Santi S.M. and Shiroma M., 1997. "In vivo and in vitro". Plasmodium falciparum resistance to chloroquine, amodiaquine and quinine in the Brazilian Amazon.Rev. Inst. Med. Trop. Sao Paulo 39:85-90
-
TDR - WHO. 1997.Progress 1995 - 96. Thirteenth Programme Report: 40-61.
-
Trager, W. and Jensen JB. 1976. Human malaria parasites in continuous culture. Science. 193:673-675
-
WHO. 1996. Climate change and human health. Ed. Micahel A., Haines, A., Slooff R. and Kovats S. WHO. Geneva. 71-105
-
Zerpa de A. N. 1993. Reseña hsitórica de los antimaláricos utilizados en Venezuela. Rev. Soc. Ven. Hist. Med 42:46-57
-
XXXII Asamblea General Ordinaria y Jornadas Científicas de la Sociedad Venezolana de Salud Pública. Mérida. Material Mimeografada MSAS p. 16.

Se ha especulado sobre el origen de la malaria en América. Algunos autores postulan que Plasmodium vivax, fue introducida por poblaciones asiáticas cuando migraron hacia América en la época precolombina por el estrecho de Behring (Knell A.. 1999). Otros, han descartado esta hipótesis sobre la base que de haberse establecido P. vivax en tierras bajas de centroamérica, probablemente no hubiera permitido el florecimiento de algunas culturas indígenas como la Maya (Gabaldón A. 1972). En el caso de Plasmodium falciparum, existe consenso en la introducción de esta especie, a través del tráfico de esclavos desde el Africa ecuatorial occidental a partir del siglo XVI (Knell A.. 1999). En relación a P. malariae, existe la controversia si esta especie corresponde a P. brasilianum, una especie de malaria de primates americanos y por lo tanto ésta, podría ser la única especie autóctona, de no haber sido introducida como ocurrió con P. falciparum. La aplicación de las modernas técnicas de biología molecular, permitirán dilucidar la mayoria de estas incógnitas, particularmente el origen y dispersión de las distintas especies de plasmodios.
Se ha especulado sobre el origen de la malaria en América. Algunos autores postulan que Plasmodium vivax, fue introducida por poblaciones asiáticas cuando migraron hacia América en la época precolombina por el estrecho de Behring (Knell A.. 1999). Otros, han descartado esta hipótesis sobre la base que de haberse establecido P. vivax en tierras bajas de centroamérica, probablemente no hubiera permitido el florecimiento de algunas culturas indígenas como la Maya (Gabaldón A. 1972). En el caso de Plasmodium falciparum, existe consenso en la introducción de esta especie, a través del tráfico de esclavos desde el Africa ecuatorial occidental a partir del siglo XVI (Knell A.. 1999). En relación a P. malariae, existe la controversia si esta especie corresponde a P. brasilianum, una especie de malaria de primates americanos y por lo tanto ésta, podría ser la única especie autóctona, de no haber sido introducida como ocurrió con P. falciparum. La aplicación de las modernas técnicas de biología molecular, permitirán dilucidar la mayoria de estas incógnitas, particularmente el origen y dispersión de las distintas especies de plasmodios. La estructuración de programas verticales de control de malaria en las distintas repúblicas latinoamericanas fueron exitosos hasta comienzos de la década de los 70. Particularmente, en Venezuela luego de la introducción del DDT en 1945, se logró disminuir las altas tasas de mortalidad de más de 200 muertes x 100.000 hab. antes de 1936, a menos de 0,2%. Sin embargo, notables éxitos se habían ya logrado antes de la aplicación del DDT con tratamientos masivos con quinina, obras de ingeniería sanitaria y el uso de insecticidas de corta duración como los piretroides (Gabaldón A. and Berti. A. L. 1954) (Pereira C. 1985).
La estructuración de programas verticales de control de malaria en las distintas repúblicas latinoamericanas fueron exitosos hasta comienzos de la década de los 70. Particularmente, en Venezuela luego de la introducción del DDT en 1945, se logró disminuir las altas tasas de mortalidad de más de 200 muertes x 100.000 hab. antes de 1936, a menos de 0,2%. Sin embargo, notables éxitos se habían ya logrado antes de la aplicación del DDT con tratamientos masivos con quinina, obras de ingeniería sanitaria y el uso de insecticidas de corta duración como los piretroides (Gabaldón A. and Berti. A. L. 1954) (Pereira C. 1985).